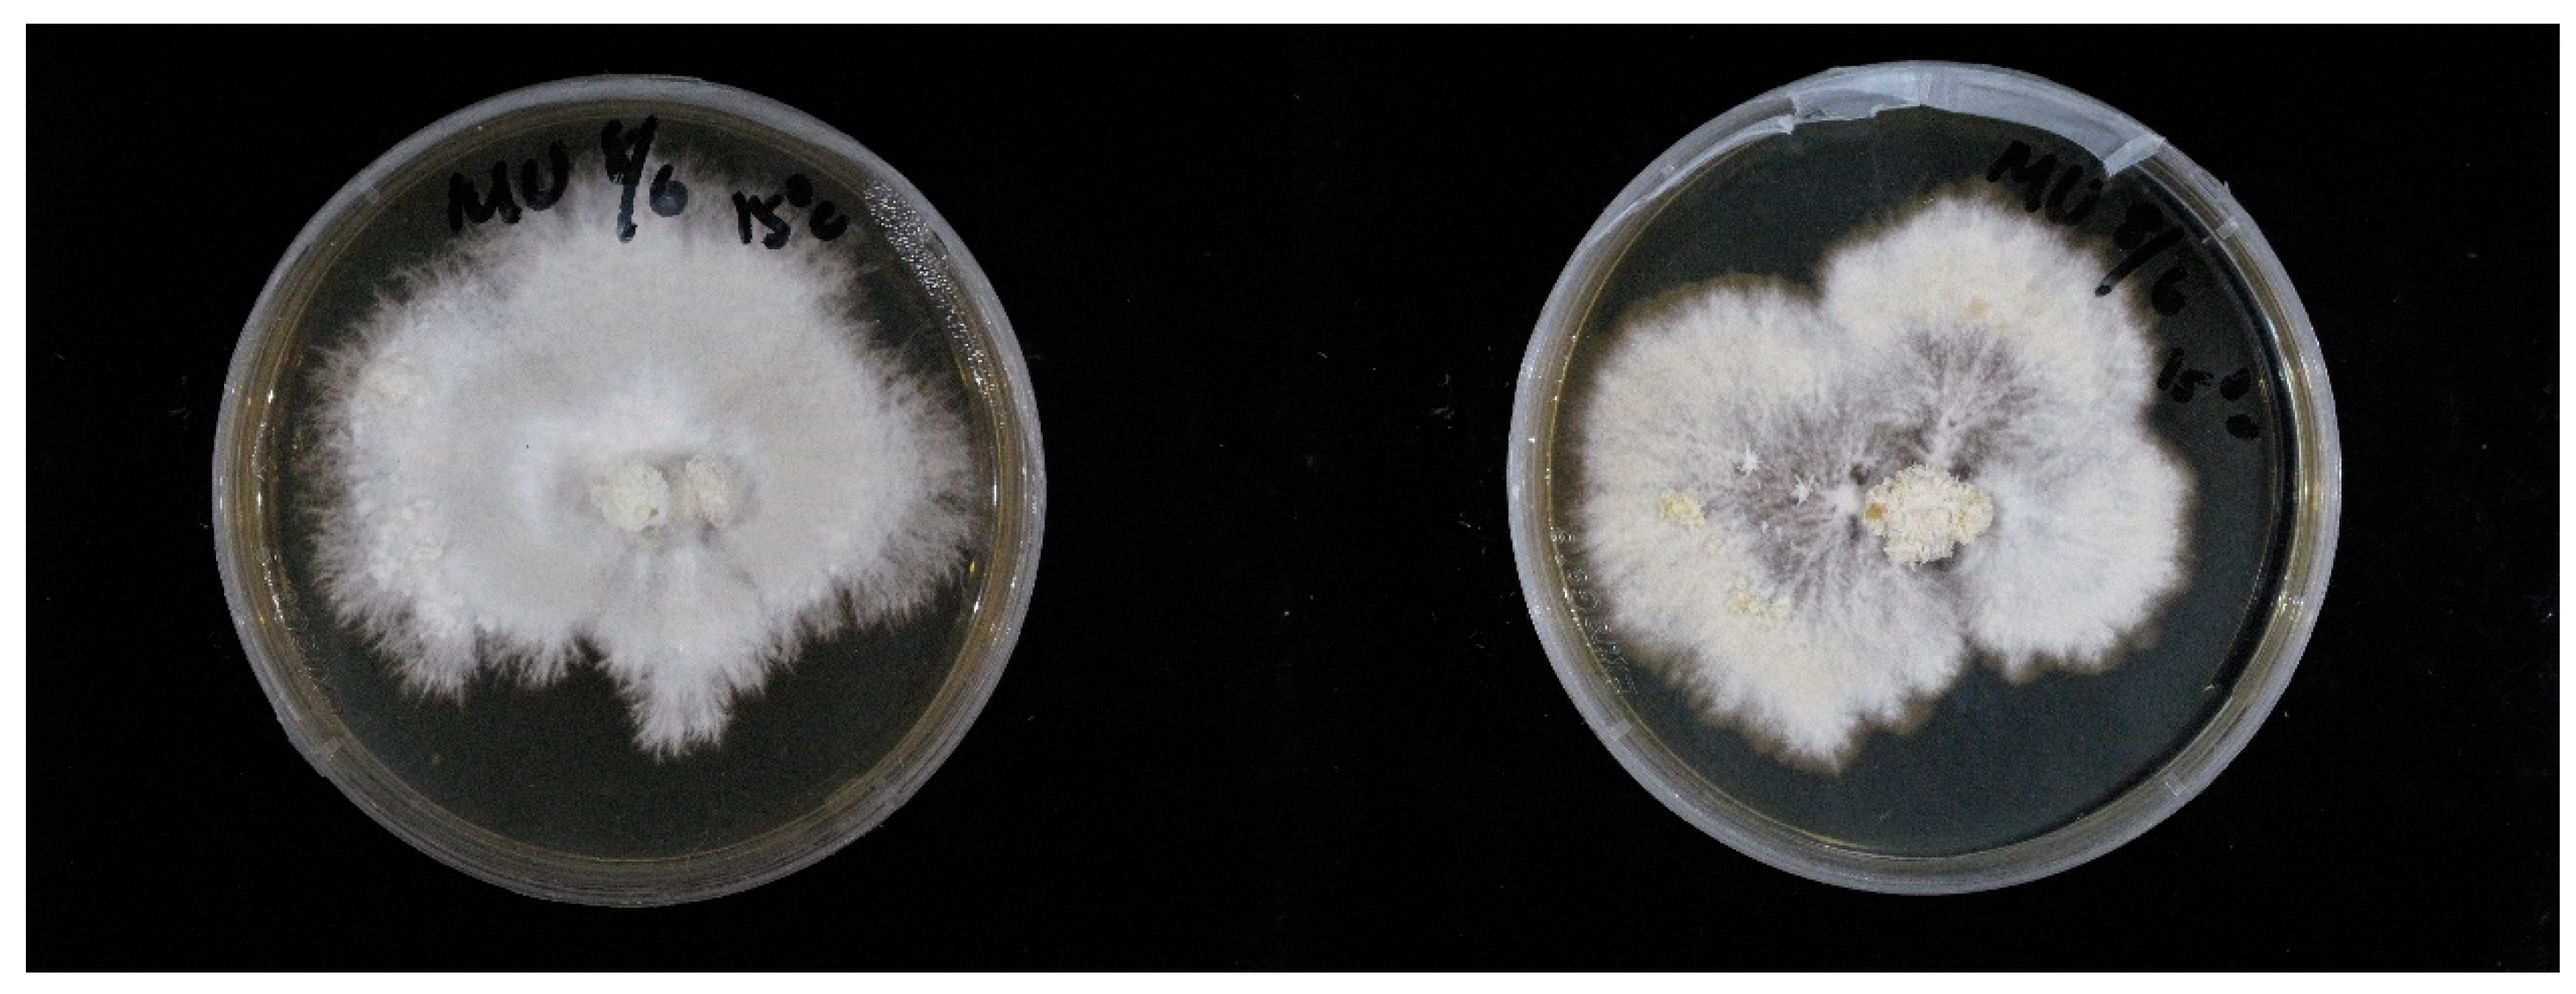
Fermentation 07 00182 g003

Enhanced Erinacine A Production by Hericium erinaceus Using Solid-State Cultivation
Abstract
:1. Introduction
2. Materials and Methods
2.1. Strain and Chemicals
2.2. Cultivation Conditions
2.3. Erinacine A Purification
2.4. Assays
2.5. Statistical Analysis
3. Results and Discussion
3.1. Solid-State Cultivation of HE in Petri Dish
3.1.1. Effect of Media on Mycelial Growth
3.1.2. Effect of Temperature on Mycelial Growth
3.2. Solid-State Cultivation of HE in Glass Jar
3.2.1. Effect of Substrate on HE Mycelial Cultivation
3.2.2. Effect of Particle Size
3.2.3. Effect of Substrate Weight
3.2.4. Effect of Nitrogen Source and Inorganic Salts
3.3. ErA Purification and Identification
3.4. Comparisons of ErA Production Using Submerged Fermentation and Solid-State Cultivation
4. Conclusions
Author Contributions
Funding
Institutional Review Board Statement
Informed Consent Statement
Data Availability Statement
Conflicts of Interest
References
- Kim, S.P.; Moon, E.; Nam, S.H.; Friedman, M. Hericium erinaceus mushroom extracts protect infected mice against Salmonella Typhimurium-Induced liver damage and mortality by stimulation of innate immune cells. J. Agric. Food Chem. 2012, 60, 5590–5596. [Google Scholar] [CrossRef]
- Thongbai, B.; Rapior, S.; Hyde, K.D.; Wittstein, K.; Stadler, M. Hericium erinaceus, an amazing medicinal mushroom. Mycol. Prog. 2015, 14, 1–23. [Google Scholar] [CrossRef]
- Yang, Y.; Zhao, C.; Diao, M.; Zhong, S.; Sun, M.; Sun, B.; Ye, H.; Zhang, T. The prebiotic activity of simulated gastric and intestinal digesta of polysaccharides from the Hericium erinaceus. Molecules 2018, 23, 3158. [Google Scholar] [CrossRef] [Green Version]
- Zhu, L.; Wu, D.; Zhang, H.; Li, Q.; Zhang, Z.; Liu, Y.; Zhou, S.; Wang, W.; Li, Z.; Yang, Y. Effects of Atmospheric and Room Temperature Plasma (ARTP) mutagenesis on physicochemical characteristics and immune activity in vitro of Hericium erinaceus polysaccharides. Molecules 2019, 24, 262. [Google Scholar] [CrossRef] [Green Version]
- Chong, P.S.; Fung, M.-L.; Wong, K.H.; Lim, L.W. Therapeutic potential of Hericium erinaceus for depressive disorder. Int. J. Mol. Sci. 2020, 21, 163. [Google Scholar] [CrossRef] [PubMed] [Green Version]
- Valu, M.-V.; Soare, L.C.; Sutan, N.A.; Ducu, C.; Moga, S.; Hritcu, L.; Boiangiu, R.S.; Carradori, S. Optimization of ultrasonic extraction to obtain erinacine a and polyphenols with antioxidant activity from the fungal biomass of Hericium erinaceus. Foods 2020, 9, 1889. [Google Scholar] [CrossRef]
- Kalaras, M.D.; Richie, J.P.; Calcagnotto, A.; Beelman, R.B. Mushrooms: A rich source of the antioxidants ergothioneine and glutathione. Food Chem. 2017, 233, 429–433. [Google Scholar] [CrossRef]
- Shen, T.; Morlock, G.; Zorn, H. Production of cyathane type secondary metabolites by submerged cultures of Hericium erinaceus and evaluation of their antibacterial activity by direct bioautography. Fungal. Biol. Biotechnol. 2015, 2, 8. [Google Scholar] [CrossRef] [PubMed] [Green Version]
- Lu, Q.-Q.; Tian, J.-M.; Wei, J.; Gao, J.-M. Bioactive metabolites from the mycelia of the basidiomycete Hericium erinaceum. Nat. Prod. Res. 2014, 28, 1288–1292. [Google Scholar] [CrossRef]
- Han, S.S.; Cho, C.K.; Lee, Y.W.; Yoo, H.S. Antimetastatic and immunomodulating effect of water extracts from various mushrooms. J. Acupunct Meridian Stud. 2009, 2, 218–227. [Google Scholar] [CrossRef] [Green Version]
- Shimbo, M.; Kawagishi, H.; Yokogoshi, H. Erinacine A increases catecholamine and nerve growth factor content in the central nervous system of rats. Nutr. Res. 2005, 25, 617–623. [Google Scholar] [CrossRef]
- Kawagishi, H.; Zhuang, C.; Yunoki, R. Compounds for dementia from Hericium erinaceum. Drugs Future 2008, 33, 149. [Google Scholar] [CrossRef]
- Li, I.-C.; Lee, L.-Y.; Tzeng, T.-T.; Chen, W.-P.; Chen, Y.-P.; Shiao, Y.-J.; Chen, C.-C. Neurohealth properties of Hericium erinaceus mycelia enriched with erinacines. Behav. Neurol. 2018, 2018, 1–10. [Google Scholar]
- Lee, K.-F.; Chen, J.-H.; Teng, C.-C.; Shen, C.-H.; Hsieh, M.-C.; Lu, C.-C.; Lee, K.-C.; Lee, L.-Y.; Chen, W.-P.; Chen, C.-C. Protective effects of Hericium erinaceus mycelium and its isolated erinacine A against ischemia-injury-induced neuronal cell death via the inhibition of iNOS/p38 MAPK and nitrotyrosine. Int. J. Mol. Sci. 2014, 15, 15073–15089. [Google Scholar] [CrossRef] [PubMed] [Green Version]
- Lee, K.-F.; Tung, S.-Y.; Teng, C.-C.; Shen, C.-H.; Hsieh, M.C.; Huang, C.-Y.; Lee, K.-C.; Lee, L.-Y.; Chen, W.-P.; Chen, C.-C. Post-treatment with erinacine A, a derived diterpenoid of H. erinaceus, attenuates neurotoxicity in MPTP model of Parkinson’s disease. Antioxidants 2020, 9, 137. [Google Scholar] [CrossRef] [Green Version]
- Li, I.; Chang, H.-H.; Lin, C.-H.; Chen, W.-P.; Lu, T.-H.; Lee, L.-Y.; Chen, Y.-W.; Chen, Y.-P.; Chen, C.-C.; Lin, D.P.-C. Prevention of early Alzheimer’s disease by erinacine A-enriched Hericium erinaceus mycelia pilot double-blind placebo-controlled study. Front. Aging Neurosci. 2020, 12, 155. [Google Scholar] [CrossRef]
- Li, I.-C.; Lee, L.-Y.; Chen, Y.-J.; Chou, M.-Y.; Wang, M.-F.; Chen, W.-P.; Chen, Y.-P.; Chen, C.-C. Erinacine A-enriched Hericium erinaceus mycelia promotes longevity in Drosophila melanogaster and aged mice. PLoS ONE 2019, 14, e0217226. [Google Scholar] [CrossRef] [PubMed]
- Chang, S.T.; Wasser, S.P. The role of culinary-medicinal mushrooms on human welfare with a pyramid model for human health. Int. J. Med. Mushrooms 2012, 14, 95–134. [Google Scholar] [CrossRef]
- Malinowska, E.; Krzyczkowski, W.; Lapienis, G.; Herold, F. Improved simultaneous production of mycelial biomass and polysaccharides by submerged culture of Hericium erinaceum: Optimization using a central composite rotatable design (CCRD). J. Ind. Microbiol. Biotechnol. 2009, 36, 1513–1527. [Google Scholar] [CrossRef]
- Ulziijargal, E.; Mau, J. Nutrient compositions of culinary-medicinal mushroom fruiting bodies and mycelia. Int. J. Med. Mushrooms 2011, 13, 343–349. [Google Scholar] [CrossRef] [PubMed]
- McKinney, K.; Combs, J.; Becker, P.; Humphries, A.; Filer, K.; Vriesekoop, F. Optimization of phytase production from Escherichia coli by altering solid-state fermentation conditions. Fermentation 2015, 1, 13–23. [Google Scholar] [CrossRef] [Green Version]
- Handa, S.; Sharma, N.; Pathania, S. Multiple parameter optimization for maximization of pectinase production by Rhizopus sp. C4 under solid-state fermentation. Fermentation 2016, 2, 10. [Google Scholar] [CrossRef] [Green Version]
- Martins, S.; Mussatto, S.I.; Martínez-Avila, G.; Montañez-Saenz, J.; Aguilar, C.N.; Teixeira, J.A. Bioactive phenolic compounds: Production and extraction by solid-state fermentation. A review. Biotechnol. Adv. 2011, 29, 365–373. [Google Scholar] [CrossRef] [PubMed] [Green Version]
- Ma, B.-J.; Shen, J.-W.; Yu, H.-Y.; Ruan, Y.; Wu, T.-T.; Zhao, X. Hericenones and erinacines: Stimulators of nerve growth factor (NGF) biosynthesis in Hericium erinaceus. Mycology 2010, 1, 92–98. [Google Scholar] [CrossRef] [Green Version]
- Krzyczkowski, W.; Malinowska, E.; Herold, F. Erinacine A biosynthesis in submerged cultivation of Hericium erinaceum: Quantification and improved cultivation. Eng. Life Sci. 2010, 10, 446–457. [Google Scholar] [CrossRef]
- Chang, C.-H.; Chen, Y.; Yew, X.-X.; Chen, H.-X.; Kim, J.-X.; Chang, C.-C.; Peng, C.-C.; Peng, R.Y. Improvement of erinacine A productivity in Hericium erinaceus mycelia and its neuroprotective bioactivity against the glutamate-insulted apoptosis. LWT-Food Sci. Technol. 2016, 65, 1100–1108. [Google Scholar] [CrossRef]
- Gerbec, B.; Tavčar, E.; Gregori, A.; Kreft, S.; Berovic, M. Solid-state cultivation of Hericium erinaceus biomass and erinacine: A production. J. Bioproces. Biotech. 2015, 5, 1–5. [Google Scholar]
- Atila, F. Lignocellulosic and proximate based compositional changes in substrates during cultivation of Hericium erinaceus mushroom. Sci. Hortic. 2019, 258, 108779. [Google Scholar] [CrossRef]
- Imtiaj, A.; Jayasinghe, C.; Lee, G.W.; Shim, M.J.; Rho, H.-S.; Lee, H.S.; Hur, H.; Lee, M.W.; Lee, U.-Y.; Lee, T.-S. Vegetative growth of four strains of Hericium erinaceus collected from different habitats. Mycobiology 2008, 36, 88–92. [Google Scholar] [CrossRef] [Green Version]
- Klamer, M.; Bååth, E. Estimation of conversion factors for fungal biomass determination in compost using ergosterol and PLFA 18: 2ω6, 9. Soil Biol. Biochem. 2004, 36, 57–65. [Google Scholar] [CrossRef]
- Boddy, L.; Crockatt, M.E.; Ainsworth, A.M. Ecology of Hericium cirrhatum, H. coralloides and H. erinaceus in the UK. Fungal Ecol. 2011, 4, 163–173. [Google Scholar] [CrossRef]
- Ko, H.G.; Park, H.G.; Park, S.H.; Choi, C.W.; Kim, S.H.; Park, W.M. Comparative study of mycelial growth and basidiomata formation in seven different species of the edible mushroom genus Hericium. Bioresour. Technol. 2005, 96, 1439–1444. [Google Scholar] [CrossRef]
- Corana, F.; Cesaroni, V.; Mannucci, B.; Baiguera, R.M.; Picco, A.M.; Savino, E.; Ratto, D.; Perini, C.; Kawagishi, H.; Girometta, C.E. Array of metabolites in Italian Hericium erinaceus mycelium, primordium, and sporophore. Molecules 2019, 24, 3511. [Google Scholar] [CrossRef] [Green Version]
- Lee, G.Y.; Li, W.; Chirwa, U.M.; Shi, J. Effect of substrate characteristics on the growth and sporulation of two biocontrol microorganisms during solid-state cultivation. Fermentation 2020, 6, 69. [Google Scholar] [CrossRef]
- Szymczak, T.; Cybulska, J.; Podleśny, M.; Frąc, M. Various perspectives on microbial lipase production using agri-food waste and renewable products. Agriculture 2021, 11, 540. [Google Scholar] [CrossRef]
- Membrillo, I.; Sánchez, C.; Meneses, M.; Favela, E.; Loera, O. Effect of substrate particle size and additional nitrogen source on production of lignocellulolytic enzymes by Pleurotus ostreatus strains. Bioresour. Technol. 2008, 99, 7842–7847. [Google Scholar] [CrossRef] [PubMed]
- Smail, T.; Salhi, O.; Knapp, J. Solid-state fermentation of carob pods by Aspergillus niger for protein production: Effect of particle size. World J. Microbiol. Biotechnol. 1995, 11, 171–173. [Google Scholar] [CrossRef]
- Osmolovskiy, A.A.; Baranova, N.A.; Kreier, V.G.; Kurakov, A.V.; Egorov, N.S. Solid-state and membrane-surface liquid cultures of micromycetes: Specific features of their development and enzyme production (a review). Appl. Biochem. Microbiol. 2014, 50, 219–227. [Google Scholar] [CrossRef]
- Stredansky, M.; Conti, E. Succinoglycan production by solid-state fermentation with Agrobacterium tumefaciens. Appl. Microbiol. Biotechnol. 1999, 52, 332–337. [Google Scholar] [CrossRef] [PubMed]
- Benabda, O.; M’hir, S.; Kasmi, M.; Mnif, W.; Hamdi, M. Optimization of protease and amylase production by Rhizopus oryzae cultivated on bread waste using solid-state fermentation. J. Chem. 2019, 2019. [Google Scholar] [CrossRef] [Green Version]
- Yu, X.H.; Gu, Z.X.; Tu, K.; Shao, R.; Jin, X.J. Optimization of solid-state fermentation media for soluble dietary fiber production by Hericium erinaceus. In Advanced Materials Research; Trans Tech Publications Ltd.: Freienbach, Switzerland, 2012; pp. 81–89. [Google Scholar]
- Bellettini, M.B.; Fiorda, F.A.; Maieves, H.A.; Teixeira, G.L.; Ávila, S.; Hornung, P.S.; Júnior, A.M.; Ribani, R.H. Factors affecting mushroom Pleurotus spp. Saudi J. Biol. Sci. 2019, 26, 633–646. [Google Scholar] [CrossRef] [PubMed]
- Lin, T.-Y.; Tseng, A.-J.; Chao, C.-H.; Lu, M.-K. Microelements induce changes in characterization of sulfated polysaccharides from Antrodia cinnamomea. Int. J. Biol. Macromol. 2018, 120, 952–958. [Google Scholar] [CrossRef] [PubMed]
- Li, I.-C.; Chen, Y.-L.; Lee, L.-Y.; Chen, W.-P.; Tsai, Y.-T.; Chen, C.-C.; Chen, C.-S. Evaluation of the toxicological safety of erinacine A-enriched Hericium erinaceus in a 28-day oral feeding study in Sprague–Dawley rats. Food Chem. Toxicol. 2014, 70, 61–67. [Google Scholar] [CrossRef] [PubMed]

| Grains Composition | Polished Rice | Corn Kernel | Adlay Kernel | Brown Rice | Red Bean | Sesame |
|---|---|---|---|---|---|---|
| Carbohydrate | 78.5 * | 72.2 | 65.9 | 76.6 | 61.5 | 17.6 |
| Protein | 6.1 | 10.9 | 13.7 | 7.4 | 20.9 | 22.2 |
| Lipid | 1.2 | 3.9 | 7.4 | 2.3 | 0.6 | 48.1 |
| water | 13.7 | 11.9 | 11.0 | 12.5 | 13.9 | 6.0 |
| Ash | 0.5 | 1.1 | 2.0 | 1.2 | 3.1 | 6.1 |
| C/N ratio | 12.87 | 6.62 | 4.81 | 10.35 | 2.94 | 0.79 |
| Strain | Culture State | Specific ErA Yield (mg/g DW) | Biomass Level 1 | ErA Production 2 | Culture Time (Day) | Ref. |
|---|---|---|---|---|---|---|
| H. erinaceum (Bull.: Fr.) Pers. | Submerged | 14.44 | 13.3 (g/L) | 192 (mg/L) | 8 | [25] |
| H. erinaceus BCRC 35669 | Submerged | 13.39 | 16.8 (g/L) | 225 (mg/L) | 8 | [26] |
| H. erinaceum BCRC 35669 | Submerged fermenter | 5 | NA 3 | NA | 12 | [17,33] |
| H. erinaceus | Solid-state, glass jar | NA | 100 (g/kg) | 225.4 × 103 AUC 4 | 56 | [27] |
| H. erinaceum MU30296 | Submerged, shake flask | 12.85 | 4.42 (g/L) | 56.80 (mg/L) | 12 | This study |
| H. erinaceum MU30296 | Petri dish | ND 5 | ND | ND | 10–15 | This study |
| H. erinaceum MU30296 | Solid-state, glass jar | 165.36 | 50.24 (g/kg) | 8.3 (g/kg) | 20 | This study |
Publisher’s Note: MDPI stays neutral with regard to jurisdictional claims in published maps and institutional affiliations. |
© 2021 by the authors. Licensee MDPI, Basel, Switzerland. This article is an open access article distributed under the terms and conditions of the Creative Commons Attribution (CC BY) license (https://creativecommons.org/licenses/by/4.0/).
Share and Cite
Cheng, P.-Y.; Liao, H.-Y.; Kuo, C.-H.; Liu, Y.-C. Enhanced Erinacine A Production by Hericium erinaceus Using Solid-State Cultivation. Fermentation 2021, 7, 182. https://doi.org/10.3390/fermentation7030182
Cheng P-Y, Liao H-Y, Kuo C-H, Liu Y-C. Enhanced Erinacine A Production by Hericium erinaceus Using Solid-State Cultivation. Fermentation. 2021; 7(3):182. https://doi.org/10.3390/fermentation7030182
Chicago/Turabian StyleCheng, Po-Yu, Hung-Yi Liao, Chia-Hung Kuo, and Yung-Chuan Liu. 2021. "Enhanced Erinacine A Production by Hericium erinaceus Using Solid-State Cultivation" Fermentation 7, no. 3: 182. https://doi.org/10.3390/fermentation7030182
APA StyleCheng, P.-Y., Liao, H.-Y., Kuo, C.-H., & Liu, Y.-C. (2021). Enhanced Erinacine A Production by Hericium erinaceus Using Solid-State Cultivation. Fermentation, 7(3), 182. https://doi.org/10.3390/fermentation7030182

